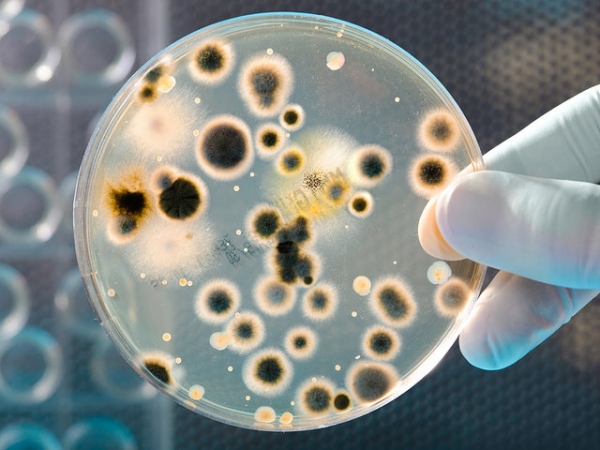
Трансплантация микробиоты — новое слово в медицине

Трансплантация микробиоты — новое слово в медицине
Трансплантация кала в лечебных целях… Мы не рискнули публиковать этот материал 1 апреля: вы бы нам не поверили. Но сейчас мы вполне серьезны!

Анна Попенко,
Кандидат биологических наук, старший научный сотрудник биомедицинского холдинга «Атлас»
Помните статью про новый орган в теле человека? Как известно, большинство отказавших органов можно заменить. Для этого существует трансплантация. Так вот, микробиоту тоже можно трансплантировать.
За рубежом вплотную подходят к тому, чтобы внести фекальную трансплантацию в медицинские гайдлайны. В России есть пока что всего один центр (в Новосибирске), где эту услугу могут предоставить пациентам, страдающим от дисбактериоза, воспалительных заболеваний кишечника или нейродегенеративных заболеваний.
О сути нового метода
Ученые не зря называют микробиоту органом человека. Разные виды бактерий не просто живут и работают в кишечнике — в процессе функционирования они выстраивают между собой сложные системы связей, и эти связи также обеспечивают множество различных важных функций. Поэтому трансплантация микробиоты — это по сути пересадка нового органа с уже работающей системой взаимосвязей.
Культуры бактерий составляют до 30% сухой массы кала. То есть вы видитесь с вашими добрыми квартирантами каждый день, можете даже помахать им рукой на прощание.
Трансплантация фекальной микробиоты — это пересадка культур нормальной кишечной микрофлоры здорового донора больному. Эта процедура помогает вытеснить из кишечника патогенные микроорганизмы, заменив их безвредными бактериями.
Клинические исследования такого экспериментального способа лечения дали положительные результаты и показали преимущество перед антибиотиками в некоторых ситуациях. Антибиотики, попадая в очаг воспаления, препятствуют размножению болезнетворных бактерий. В результате такого лечения состояние может не только не улучшиться, но даже и ухудшиться, потому что нормальная микрофлора кишечника не восстановлена.
Исследования на эту тему в Амстердамском Университете показало явное преимущество трансплантации перед стандартной антибиотикотерапией. В группе добровольцев, получавших антибиотики, выздоровели 26%. В группе, которую лечили пересадкой микробиоты, выздоровели 93%.
Копрофагия (поедание собственных или чужих экскрементов) характерна для кроликов и считается здоровым процессом: кролики каждые сутки съедают часть своего кала. Если же кто-то из них заболевает, он может начать есть экскременты своих здоровых соседей, чтобы восстановиться.
1
/
3
О показаниях к применению
